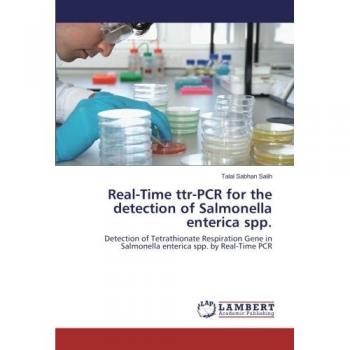

Gesponsert Diese Website enthält Affiliate-Links, für die wir möglicherweise eine Vergütung erhalten. Weitere Informationen
213.99 EUR
213.99 EUR
30-04-2026 00:43:36
213.99 EUR
213.99 EUR
29-04-2026 17:23:29